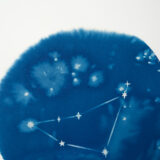

Émerveille-toi chaque jour, avec un bout de ciel sur tes murs. Une invitation à rêver et à contempler le monde qui t’entoure !
- À domicile
- En point relais La Poste,
- Et en point de retrait Mondial Relay.
- Le papier utilisé est fabriqué en France avec 100% cellulose, certifié FSC, garanti sans acide ni azurant optique, non blanchi, afin de limiter au maximum l’empreinte de mes créations sur l’environnement.
- Concernant l’encadrement à la main, les matériaux que j’utilise sont eux aussi choisis pour être le plus respectueux possible de l’environnement, et proche des matériaux utilisés dans les musées pour les tirages d’art. À savoir, traité sans acide et avec un PH neutre pour assurer la durabilité du tirage dans le temps.
- Évite de placer ton cyanotype à la lumière directe du soleil de façon prolongée ! Comme tous les pigments, le bleu peut s’éclaircir. En revanche, si cela fini par arriver, pas de panique : place-le dans l'obscurité et au contact de l'air pendant quelques jours, le bleu retrouvera toute son intensité !
- Le cyanotype a cette propriété "magique" et fait parti des procédés photo qui se conservent le mieux dans le temps.
Description
Tirage cyanotype d’une illustration de constellation, représentant la constellation du capricorne, sur papier aquarelle 300g.
Pour ces tirages, l’emplacement des étoiles autres que celles de la constellation n’est JAMAIS le même, ce qui les rend particulièrement uniques.
Le nom des constellations, lui, est ajouté au feutre, tirage par tirage.
Plusieurs formats sont disponibles : marque-page (5 x 20cm), A5 (15 x 21cm) ou A4 (21 x29,7 cm), ce dernier peut-être choisi avec ou sans encadrement.
- Chaque tirage est fabriqué à la commande, et pressé à froid du petit nuage du LABO, à la fois comme signature et comme garantie d’authenticité et d’originalité du tirage.
- Tu ne recevras pas le tirage exact photographié mais un cyanotype réalisé spécialement pour toi !
- Délai de fabrication et d’expédition : 7 à 10 jours ouvrés maximum
- Note également que mes encadrements ne sont pas sous verre, j’ai fais ce choix pour que tu puisses profiter pleinement du grain du papier et de l’intensité des bleus de ton cyanotype sans aucun reflet.
| Marque-pages : | 5 x 15 cm |
| Mini format : | 10 x 15 cm |
| Mini format encadré : | 13 x 18 cm |
| A5 : | 15 x 21 cm |
| A4 : | 21 x 29,7 cm |
| A4 encadré : | 25 x 34 cm |
| A3 : | 29,7 x 42 cm |
| A3 encadré : | 36 x 48 cm |

Il n'y a pas encore d'avis sur ce produit.